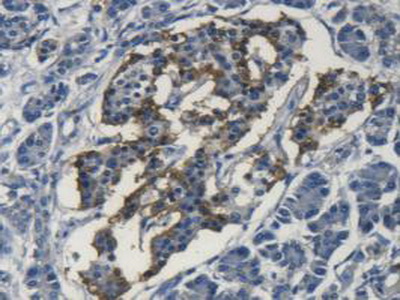
https://d1vffmuvmgkypt.cloudfront.net/image/ridacom_ltd/cloud_clone_corp/PRODUCT_SOURCE__CLOUD_CLONE__SUPPLIER__RIDACOM__ID__PAA117Hu01__2

Antigen
SOD-3
Reactivity
Mouse
(6)
Human
(4)
Rat
(3)
Rabbit
(2)
Application
Sort
Western Blotting
(10)
Immunocytochemistry
(6)
Immunohistochemistry
(6)
Enzyme-linked immunosorbent assay for Antigen Detection
(4)
Positive Control
(4)
SDS-PAGE
(4)
Immunoprecipitation
(2)
Chemiluminescent immunoassay for antigen detection
(1)
ELISA
(1)
IHC-P
(1)
Immunofluorescence
(1)
Host
Rabbit
(3)
CHO
(2)
293F
(1)
Category
Antibodies
(6)
ELISA Kits
(5)
Cell biology
(4)
Immunochemicals
(4)
Protein Biochemistry
(4)
| 48T | $605.00 | |
| 96T | $864.00 | |
| 96T*5 | $3,888.00 |
| 96T*10 | $7,344.00 | |
| 96T*100 | $60,480.00 |
| 48T | $479.00 | |
| 96T | $684.00 | |
| 96T*5 | $3,078.00 |
| 96T*10 | $5,814.00 | |
| 96T*100 | $47,880.00 |
| 48T | $479.00 | |
| 96T | $684.00 | |
| 96T*5 | $3,078.00 |
| 96T*10 | $5,814.00 | |
| 96T*100 | $47,880.00 |
| 48T | $454.00 | |
| 96T | $648.00 | |
| 96T*5 | $2,916.00 |
| 96T*10 | $5,508.00 | |
| 96T*100 | $45,360.00 |
| 48T | $441.00 | |
| 96T | $630.00 | |
| 96T*5 | $2,835.00 |
| 96T*10 | $5,355.00 | |
| 96T*100 | $44,100.00 |

Antigen:
Superoxide Dismutase 3, Extracellular
Synonyms: SOD-3; EC-SOD; Extracellular Superoxide Dismutase Cu-Zn
Reactivity:Mouse
Application:Positive Control; SDS-PAGE; Western Blotting
Research area:Enzyme & Kinase
Preparation method:Escherichia coli
| 10µg | $208.00 | |
| 50µg | $520.00 | |
| 200µg | $1,040.00 |
| 1mg | $3,120.00 | |
| 5mg | $7,800.00 |

Antigen:
Superoxide Dismutase 3, Extracellular
Synonyms: SOD-3; EC-SOD; Extracellular Superoxide Dismutase Cu-Zn
Reactivity:Rabbit
Application:Positive Control; SDS-PAGE; Western Blotting
Research area:Enzyme & Kinase
Preparation method:Escherichia coli
| 10µg | $183.00 | |
| 50µg | $458.00 | |
| 200µg | $916.00 |
| 1mg | $2,748.00 | |
| 5mg | $6,870.00 |

Antigen:
Superoxide Dismutase 3, Extracellular
Synonyms: SOD-3; EC-SOD; Extracellular Superoxide Dismutase Cu-Zn
Reactivity:Rat
Application:Positive Control; SDS-PAGE; Western Blotting
Research area:Enzyme & Kinase
Preparation method:Escherichia coli
| 10µg | $148.00 | |
| 50µg | $370.00 | |
| 200µg | $740.00 |
| 1mg | $2,220.00 | |
| 5mg | $5,550.00 |

Antigen:
Superoxide Dismutase 3, Extracellular
Synonyms: SOD-3; EC-SOD; Extracellular Superoxide Dismutase Cu-Zn
Host:293F
Reactivity:Mouse
Application:Western Blotting; Immunohistochemistry; Immunocytochemistry; Immunofluorescence
Research area:Enzyme & Kinase
| 20µl | $116.00 | |
| 100µl | $272.00 | |
| 200µl | $388.00 |
| 1ml | $970.00 | |
| 10ml | $3,880.00 |

Antigen:
Superoxide Dismutase 3, Extracellular
Synonyms: SOD-3; EC-SOD; Extracellular Superoxide Dismutase Cu-Zn
Host:CHO
Reactivity:Mouse
Application:Western Blotting; Immunohistochemistry; Immunocytochemistry
Research area:Enzyme & Kinase
| 20µl | $107.00 | |
| 100µl | $249.00 | |
| 200µl | $356.00 |
| 1ml | $890.00 | |
| 10ml | $3,560.00 |

Antigen:
Superoxide Dismutase 3, Extracellular
Synonyms: SOD-3; EC-SOD; Extracellular Superoxide Dismutase Cu-Zn
Reactivity:Human
Application:Positive Control; SDS-PAGE; Western Blotting
Research area:Enzyme & Kinase
Preparation method:Escherichia coli
| 10µg | $98.00 | |
| 50µg | $246.00 | |
| 200µg | $492.00 |
| 1mg | $1,476.00 | |
| 5mg | $3,690.00 |

Antigen:
Superoxide Dismutase 3, Extracellular
Synonyms: SOD-3; EC-SOD; Extracellular Superoxide Dismutase Cu-Zn
Host:CHO
Reactivity:Human
Application:Western Blotting; Immunohistochemistry; Immunocytochemistry
Research area:Enzyme & Kinase
| 20µl | $104.00 | |
| 100µl | $242.00 | |
| 200µl | $346.00 |
| 1ml | $865.00 | |
| 10ml | $3,460.00 |

Antigen:
Superoxide Dismutase 3, Extracellular
Synonyms: SOD-3; EC-SOD; Extracellular Superoxide Dismutase Cu-Zn
Host:Rabbit
Reactivity:Rat
Application:Western Blotting; Immunohistochemistry; Immunocytochemistry; Immunoprecipitation
Clonality:Polyclonal
Research area:Enzyme & Kinase
| 20µl | $103.00 | |
| 100µl | $239.00 | |
| 200µl | $342.00 |
| 1ml | $855.00 | |
| 10ml | $3,420.00 |

Antigen:
Superoxide Dismutase 3, Extracellular
Synonyms: SOD-3; EC-SOD; Extracellular Superoxide Dismutase Cu-Zn
Host:Rabbit
Reactivity:Mouse
Application:Western Blotting; Immunohistochemistry; Immunocytochemistry; Immunoprecipitation
Clonality:Polyclonal
Research area:Enzyme & Kinase
| 20µl | $97.00 | |
| 100µl | $227.00 | |
| 200µl | $324.00 |
| 1ml | $810.00 | |
| 10ml | $3,240.00 |

Antigen:
Superoxide Dismutase 3, Extracellular
Synonyms: SOD-3; EC-SOD; Extracellular Superoxide Dismutase Cu-Zn
Host:Rabbit
Reactivity:Human
Application:Western Blotting; Immunocytochemistry; IHC-P; Immunohistochemistry; ELISA
Clonality:Polyclonal
Research area:Enzyme & Kinase
| 20µl | $95.00 | |
| 100µl | $221.00 | |
| 200µl | $316.00 |
| 1ml | $790.00 | |
| 10ml | $3,160.00 |







-SEA117Ra-000001.png)



-E90117Rb-000001.png)



-SEA117Mu-000001.png)



-SEA117Hu-000001.png)

-RPA117Mu01-000001.png)






-RPA117Hu01-000001.png)










-PAA117Mu01-000001.png)

-PAA117Hu01-000001.png)